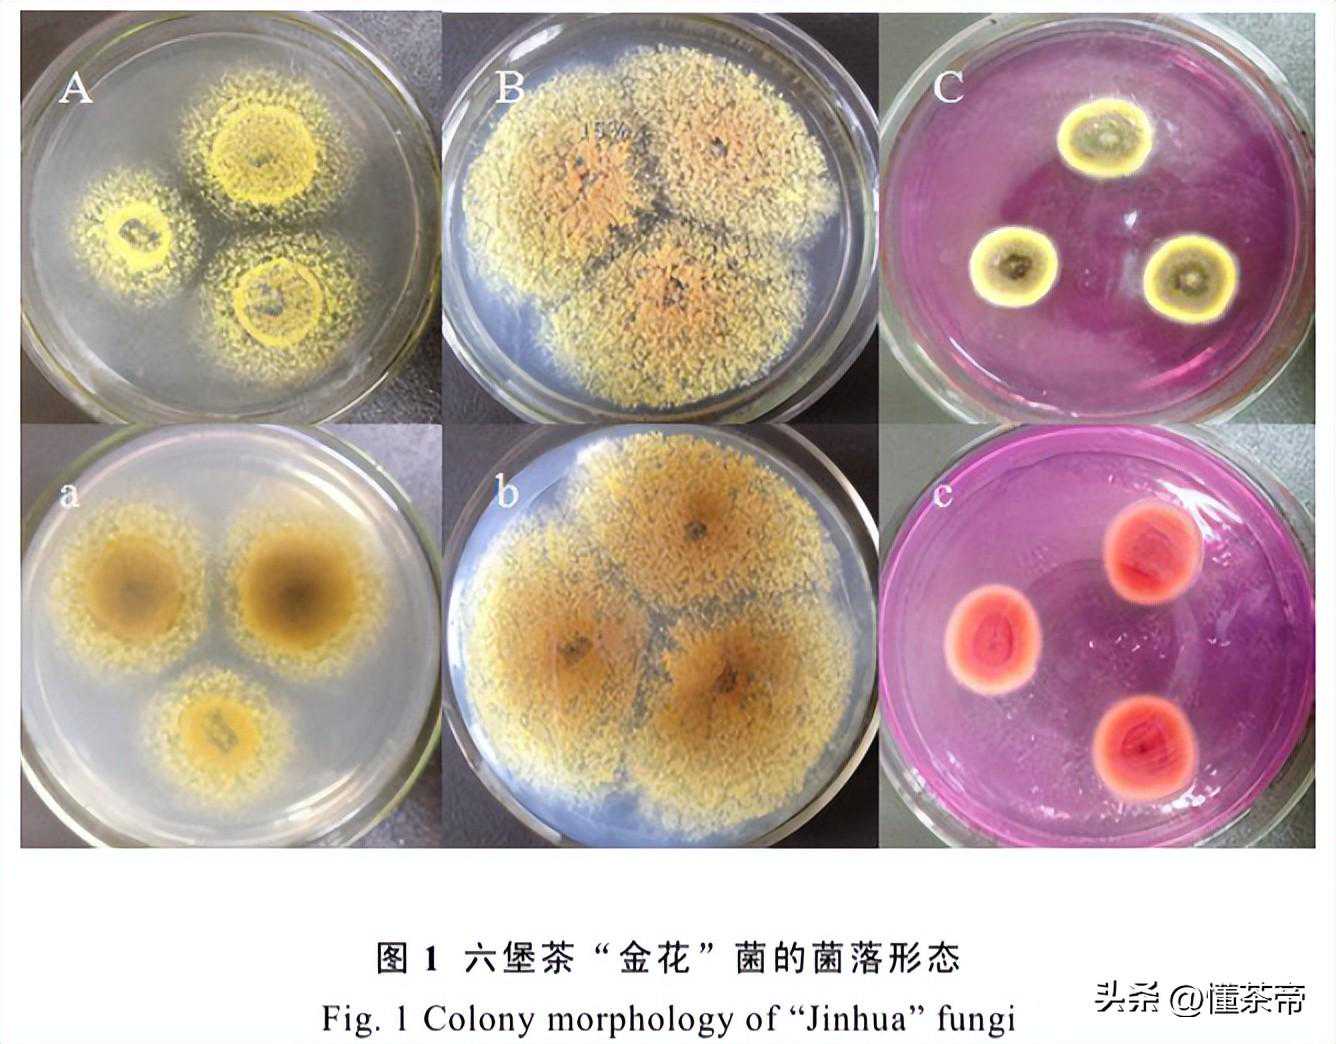

您现在的位置是:首页 > 茗茶风向
什么?六堡茶居然也能长金花
茶语播报
2025-03-13【茗茶风向】55人已围观
简介金花,是茶叶中的一种有益菌,有降脂减压、调节肠道及糖类代谢等作用,同时还能去除茶叶的粗青味,提升茶汤品质。说到金花,大家首先浮现在脑海的应该是茯砖茶,因为它是必须有发花工艺的一款黑茶。但,长金花的六堡茶,你可曾遇到过?我们知道,好的六堡茶具备“红浓陈醇”的特点,而陈年精品六堡还会有槟榔香,间有金花。...

金花,是茶叶中的一种有益菌,有降脂减压、调节肠道及糖类代谢等作用,同时还能去除茶叶的粗青味,提升茶汤品质。

说到金花,大家首先浮现在脑海的应该是茯砖茶,因为它是必须有发花工艺的一款黑茶。
但,长金花的六堡茶,你可曾遇到过?
我们知道,好的六堡茶具备“红浓陈醇”的特点,而陈年精品六堡还会有槟榔香,间有金花。
那么,六堡茶的金花是怎么长出来的?它和茯砖的金花又有什么区别呢?
01
六堡茶在加工过程中,并没有专门的发花工序,而是在陈放过程中,受湿热条件及微生物的影响,随机发生的。
六堡茶渥堆往往需要1~2个月,之后高温汽蒸装进竹篓,渥堆提供了内在物质转化的基础,在之后的陈放期,才会逐渐长出金花。

六堡茶的“金花”,金黄圆润,叶片上、缝隙上、茶梗四周均有着生。
更为奇妙的是,同一批次加工出来的六堡茶陈放时,由于所处的位置、温度、湿度等不同,金花的长势和大小也不同,有一些金花很茂盛,有些则不明显,甚至几乎看不到金花。
除此之外,六堡茶砖、茶饼比散茶更容易发花,即使是篓装六堡茶,茶篓中间比边缘要容易发花。
所以,并不是所有的六堡茶都有金花,即便是同一批茶,也不一定都会产生金花,更显得六堡茶的金花可遇不可求。
02
接下来,我们简单说下六堡茶与茯砖茶的金花有何不同。
首先是发花方式。茯砖茶属于人为发花,可控性更强;六堡茶是自然陈放发花,更具有随机性。
其次,二者菌种不同。研究者通过分离金花菌的菌种后发现,茯砖茶的金花是冠突散囊菌,而六堡茶的金花是雪黄散囊菌;
第三,茯砖茶金花更茂盛,更明显;六堡茶由于是随机生成,所以更偏细小一些。
很赞哦!(39)